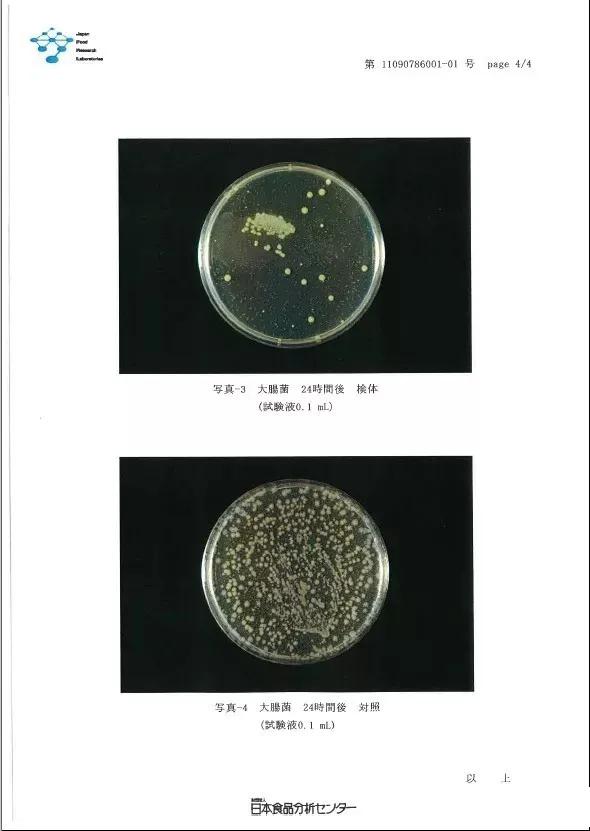
安信纯实木怎么样,安信实木老榆木

| 芬多精 |
是什么?
芬多精是国际通用名词(英文名Pythoncidere),是前苏联列宁格勒大学B.P.Toknnh博士于1930年提出的研究报告,python意为植物,cidere意为消灭。
当时Toknnh博士将高等植物的叶子切碎后放置在阿米巴之类的原生动物或白喉, 伤寒, 霍乱等细菌旁边, 数分钟后该病原菌都会被杀灭殆尽. 由此可以证实高等植物本身可分泌出杀灭病原菌的物质. 而这种天然物质就是芬多精。

芬多精的功能
近现代,人们在越来越多的科学实验中发现了芬多精强大的空气净化作用:杀菌、分解甲醛、除臭除异味等。

【杀菌】
在杀菌方面,我们知道俄罗斯的Tokin博士因为捣碎后的植物气味灭*伤杀**寒、霍乱、白喉等病菌才发现了芬多精,这已经说明他在杀菌方面的作用。
近现代,人们发现了芬多精在净化空气方面更多的功效,主要表现在对黄色葡萄球菌、大肠杆菌等这些常见菌种的杀菌效果。日本食品分析中对木材里的芬多精进行杀菌的检测结果表明,对黄色葡萄球菌的杀菌率达到99.9%。另一份检测报告结果表明了对大肠杆菌的杀菌率。如下图:

【分解甲醛】
关于芬多精除甲醛有两份检测报告:
一份是台湾SGS(超微量安全实验室)的,他们在1立方米的测试箱中,先置入甲醛气体,后面每30分钟喷淋一次木材芬多精,2小时后检测发现,甲醛浓度从20ppm降至13ppm,甲醛去除率达到33.3%。
另外深圳市计量质量检测研究所也做过类似的实验,他们在1立方米的测试箱中滴入0.24mg的甲醛,之后开始雾化木材芬多精200ml,24小时以后测试发现,甲醛分解率达到54%。

两个报告都清楚地说明芬多精分解甲醛的作用和效果。
【除臭除异味】
在除臭除异味方面,我们常见的臭味主要有体臭、宠物的体臭、垃圾臭、还有香烟的异味等。在这方面看到日本食品分析中心对木材芬多精的一份检测报告非常能够说明问题,其对臭味的主要成分异戊酸和三甲胺的消臭率分别达到99%和90%以上。



需要特别注意的是,芬多精除臭除异味与其他空气清新剂最大的区别是没有二次化学污染,他是纯植物物理萃取。另外与香水的区别是他能够对臭源进行分解,而不是覆盖或者包裹。
芬多精在哪儿
看到这儿,有朋友可能想问,芬多精难道只存在于桧木中吗?
当然不是
桧木的产区极其有限,仅见于北美、日本及台湾阿里山区,可以说是日本和台湾的特产。

芬多精的主要成分是terpene,是一种芳香性碳氢化合物. 普遍存在于树木的根、茎、叶之中, 不断释放保护自己,树龄越久的树木芬多精的浓度越高, 质量也更佳优良,所以在久居城市的人们,一旦进入森林之中就会立刻感受到清新的空气及清凉的感觉,这种感受就是芬多精起到的作用,让人舒缓疲劳愉悦心情。

安信地板在近些年引进日本桧木,进行全屋桧木整木定制服务,受到了众多业主朋友的好评,如果你也对芬多精极含量极高的橡木感兴趣,您也可以至安信地板门店咨询,或者直接留言留下您的联系方式,我们会尽快为您提供解决方案。
你家里的芬多精
芬多精在森林里,芬多精也在你家里,只要你家里铺上实木地板。是的,木头中含有丰富的天然芬多精,很多健身中心、养生会所铺设纯实木地板,除了其舒适的触感,也有其静气养神的因素,甚至于有些养生会所还会燃起一缕檀香。

安信地板专注木材26年,在全球拥有丰富的木材资源,开拓木材的脚步遍布南美、北美、非洲、东欧、东南亚等地,安信地板精选野生、百年优质原木为大家打造舒适、健康的木地板。万木之王柚木、红木典藏非洲花梨、暗香浮动的香脂木豆、稳定性强可用于地热地暖环境的茚茄木、铁苏木等等。

在我国,越是对品质生活有要求的人越是喜欢纯实木,天然木头具备的很多天然特性都正是我们所需要的,除了芬多精,你还知道哪些呢?评论区秀一下吧。

安信地板26年专注诠释环保生活
品位,奢华,精致,优雅
实现生活艺术化给您订制健康的生活品质........